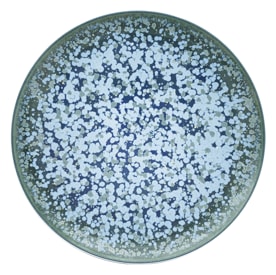
Jaune de Chrome, Nymphéa, Coupe 29cm plate, 2011

Nymphéa
Jaune de Chrome's Nymphéa dinnerware collection mixes impressionism art style with high-level craft. It is inspired by the artist Monet and shows a gentle blend of blue and green colors on white Limoges porcelain. This china collection is decorated with enamels put on by experts, making the dinner items not just useful but also beautiful things to talk about.
Nymphéa's design is in harmony and strong, showing Jaune de Chrome's commitment to both beauty and usefulness. It makes eating times special and shows the brand's love for lasting and artistic table items.
123
Other Jaune de Chrome collections
Jaune de Chrome
Song Ocean
The Song Ocean dinnerware collection by Jaune de Chrome brings to life the calm allure of a sea breeze. This...
Jaune de Chrome
Bolero Blue
Indulge in the allure of exquisite fine china with Jaune de Chrome's Bolero Blue dinnerware collection. Jaune de...
Jaune de Chrome
Song Amande
Savor the revitalizing aura of a gentle zephyr with Jaune de Chrome's Song Amande dinnerware collection...
Jaune de Chrome
Song Perle
Song Perle, a luxurious collection by Jaune de Chrome, showcases the artistry and expertise that have made the brand...
Our top brands